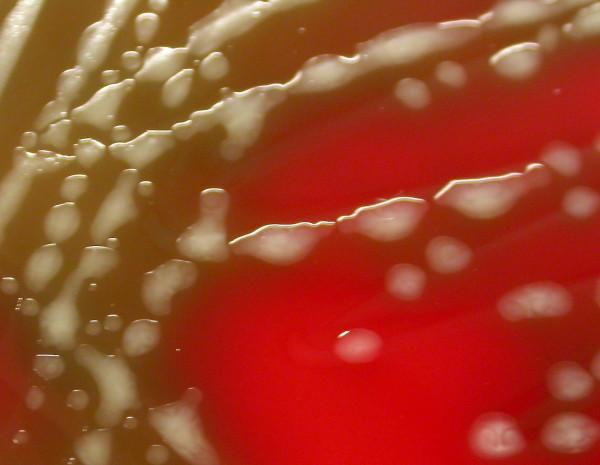

高黏液性酿脓链球菌emm3/ST15 克隆的传播。
Spread of a highly mucoid Streptococcus pyogenes emm3/ST15 clone.
机构信息
Biomedical Research Centre Network for Respiratory Diseases (CIBERES), San Sebastián, Spain.
出版信息
BMC Infect Dis. 2010 Aug 5;10:233. doi: 10.1186/1471-2334-10-233.
BACKGROUND
Hyaluronic acid capsule plays a key role in Streptococcus pyogenes virulence. Circulation of mucoid or highly encapsulated strains has been related to rheumatic fever epidemics and invasive disease in several countries. In 2009, an outbreak of mucoid S. pyogenes isolates was detected in northern Spain. The aim of the study was to describe clinical and molecular characteristics of mucoid strains causing this outbreak and to compare them with a sample of non-mucoid S. pyogenes isolates obtained during the same period of time.
METHODS
All S. pyogenes isolates with a mucoid colony morphology (n = 132), 10% of non-mucoid (n = 144) and all invasive S. pyogenes isolates (n = 7) obtained in 2009 were included. Characterization was performed by T-agglutination, emm typing, pulsed field gel electrophoresis and multilocus sequence typing.
RESULTS
One clone characterized as emm3.1/ST15 comprised 98.5% (n = 130) of all mucoid isolates. Subjects of all ages were affected. Main clinical manifestations were pharyngitis and scarlet fever, but this clone also caused invasive disease: two cases of streptococcal toxic shock syndrome, one arthritis, and one celullitis with a fatal outcome. Mucoid isolates were more prone to cause invasive disease than non-mucoid isolates (p = 0.001).
CONCLUSIONS
Although no acute rheumatic fever cases were detected, the most worrisome characteristics of this clone were the success for causing invasive disease and the merge of two virulent features: the serotype, emm3, and capsule hyper-production, expressed as a mucoid morphology.
背景
透明质酸胶囊在酿脓链球菌的毒力中起着关键作用。在多个国家,黏液型或高荚膜菌株的循环与风湿热流行和侵袭性疾病有关。2009 年,在西班牙北部发现了黏液型酿脓链球菌的爆发。本研究旨在描述引起此次暴发的黏液型菌株的临床和分子特征,并将其与同期获得的非黏液型酿脓链球菌分离株进行比较。
方法
我们选取了所有具有黏液状菌落形态的酿脓链球菌分离株(n=132)、10%的非黏液型(n=144)和所有侵袭性酿脓链球菌分离株(n=7),这些菌株均于 2009 年获得。通过 T 凝集试验、emm 分型、脉冲场凝胶电泳和多位点序列分型进行鉴定。
结果
一个克隆被鉴定为 emm3.1/ST15,包含了 98.5%(n=130)的所有黏液型分离株。所有年龄段的患者均受到影响。主要的临床表现为咽炎和猩红热,但该克隆也引起了侵袭性疾病:两例链球菌中毒性休克综合征,一例关节炎,一例蜂窝织炎,其中一例导致死亡。与非黏液型分离株相比,黏液型分离株更易引起侵袭性疾病(p=0.001)。
结论
尽管没有发现急性风湿热病例,但该克隆最令人担忧的特征是成功引起侵袭性疾病,以及两种毒力特征的融合:血清型 emm3 和荚膜过度产生,表现为黏液样形态。